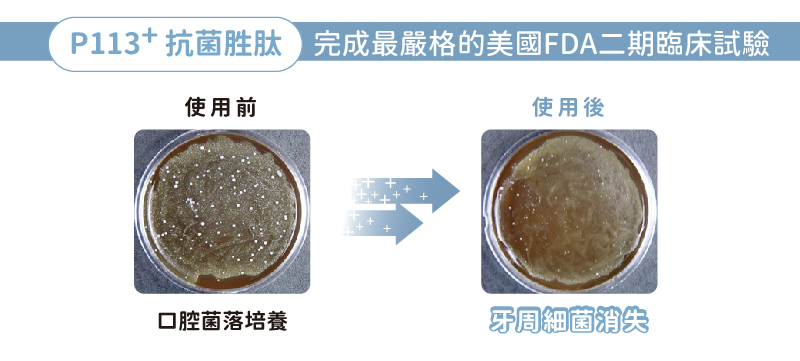

{{ 'fb_in_app_browser_popup.desc' | translate }} {{ 'fb_in_app_browser_popup.copy_link' | translate }}
{{ 'in_app_browser_popup.desc' | translate }}
有了這支再也不用擔心被寶寶咬手
輕鬆和奶垢舌苔說掰掰
口腔清潔棉棒
‧ 每支皆獨立包裝,安全無菌攜帶方便
‧ 無毒性泡棉,歐盟RoHS檢驗品質保證
‧ 零死角設計,物理性壓合,無黏膠無漂白劑
兒童漱口水(原味)/兒童護齒噴霧(原味)
‧ 添加美國獨家專利P113+抗菌胜肽
‧ 去壞留好 對抗口腔細菌
‧ 食品級成分 無添加有害化學成分
‧ 無添加薄荷 蠶豆症寶寶安心使用
點我看新生兒口腔清潔攻略
組合內含:
口腔清潔棉棒30入/袋*2
兒童漱口水(原味)350ml*1
兒童護齒噴霧(原味)20ml*1
至2026-03-31T16:00:00.000+00:00截止 指定商品,<小牙養成計畫> 購買寶寶口腔清潔全護組 贈抗菌潔膚濕紙巾80抽
至2026-03-31T16:00:00.000+00:00截止 全店,<口腔月限定加碼> 3/26-3/31全館消費滿699免運
至2026-03-31T16:00:00.000+00:00截止 全店,<3/2-3/31小牙養成計畫> 滿 2,000送鈣樂多成長果凍 ( 數量有限 ; 贈完為止 )
至2026-03-31T16:00:00.000+00:00截止 全店,<3/2-3/31小牙養成計畫> 滿3299送兒童漱口水(葡萄-國際版)x1
至2026-03-31T16:00:00.000+00:00截止 全店,<3/2-3/31小牙養成計畫> 滿 2,599送兒童護齒噴霧(柑橘-國際版)20ml
至2026-03-31T16:00:00.000+00:00截止 全店,<3/2-3/31小牙養成計畫> 滿$2,699折269 ; 滿$3,699折369
至2026-03-31T16:00:00.000+00:00截止 全店,<3月限定> 滿999免運
全店,PackAge+ 循環包裝費用另計,加購價為30元
以優惠價加購商品 (最多 {{ addItemQuantity }} 件)
商品存貨不足,未能加入購物車
您所填寫的商品數量超過庫存
{{'products.quick_cart.out_of_number_hint'| translate}}
{{'product.preorder_limit.hint'| translate}}
每筆訂單限購 {{ product.max_order_quantity }} 件
現庫存只剩下 {{ quantityOfStock }} 件